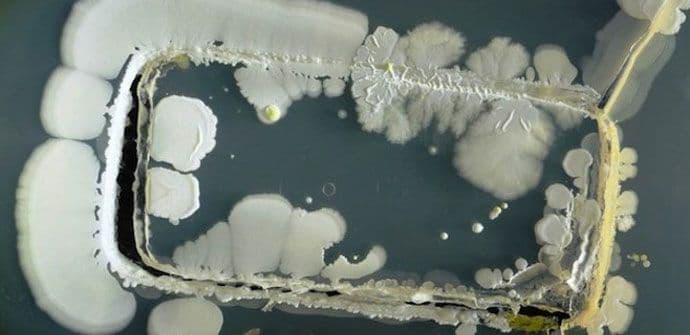
Mobilni telefoni u potpunosti prekriveni bakterijama Mobilni telefoni u potpunosti prekriveni bakterijama

Studenti sa univerziteta u Sureju su svoje mobilne telefone stavili u petrijevu posudu (posude koje biolozi koriste za ćelijske kulture), nakon čega su uvidjeli kako su touch screenovi u potpunosti prekriveni bakterijama.
Baš kao na ostacima hrane ili kompjuterskoj tastaturi, bakterije se mogu pojaviti na bilo kojoj površini, pa tako i površini telefona i na taj način dalje biti prenesene kontaktom.
Biolog dr. Sajmon Park je u izjavi za medije napisao kako bakterije pokazuju da svaki telefon ustvari sadrži istoriju svega što je ta osoba ikad u životu dotaknula.
"Sudeći na osnovu naših rezultata, izgleda da telefoni ne pamte samo telefonske brojeve, nego pohranjuju i istoriju ličnih fizičkih kontakata između ljudi i predmeta", pojasnio je Park.
I iako je većina bakterija koje su pronađene na telefonima bila bezazlena, detektovane su i manje količine bakterije stafilokok, koja može uzrokovati ozbiljne infekcije i najčešće se nastanjuje u nosu.
Najveći broj bakterija je uočen na mjestu home dugmeta, što pokazuje kako je upravo palac taj koji je najviše "kontaminiran".
Izvor i foto: klix.ba